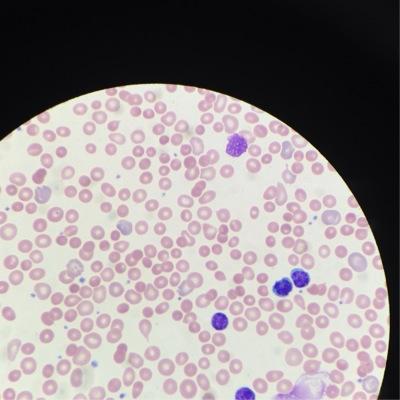

Some Sports Show Youtube @SOMESPORTSSHOW
This Is Some Sports Shows official YouTube Twitter Handle! run by @CLeMeyerson youtu.be/T7iKVB0YA1M Joined March 2015-
Tweets75
-
Followers101
-
Following678
-
Likes49
Trends for United States
23,9 B posts
37,8 B posts
32,2 B posts
31,1 B posts
12,2 B posts
35,3 B posts
10,9 B posts
22,5 B posts
5.869 posts
118 B posts
70,9 B posts
17 B posts
5.222 posts
6.829 posts
12,9 B posts
1.972 posts
85 B posts
2.167 posts
55,1 B posts
3.660 posts